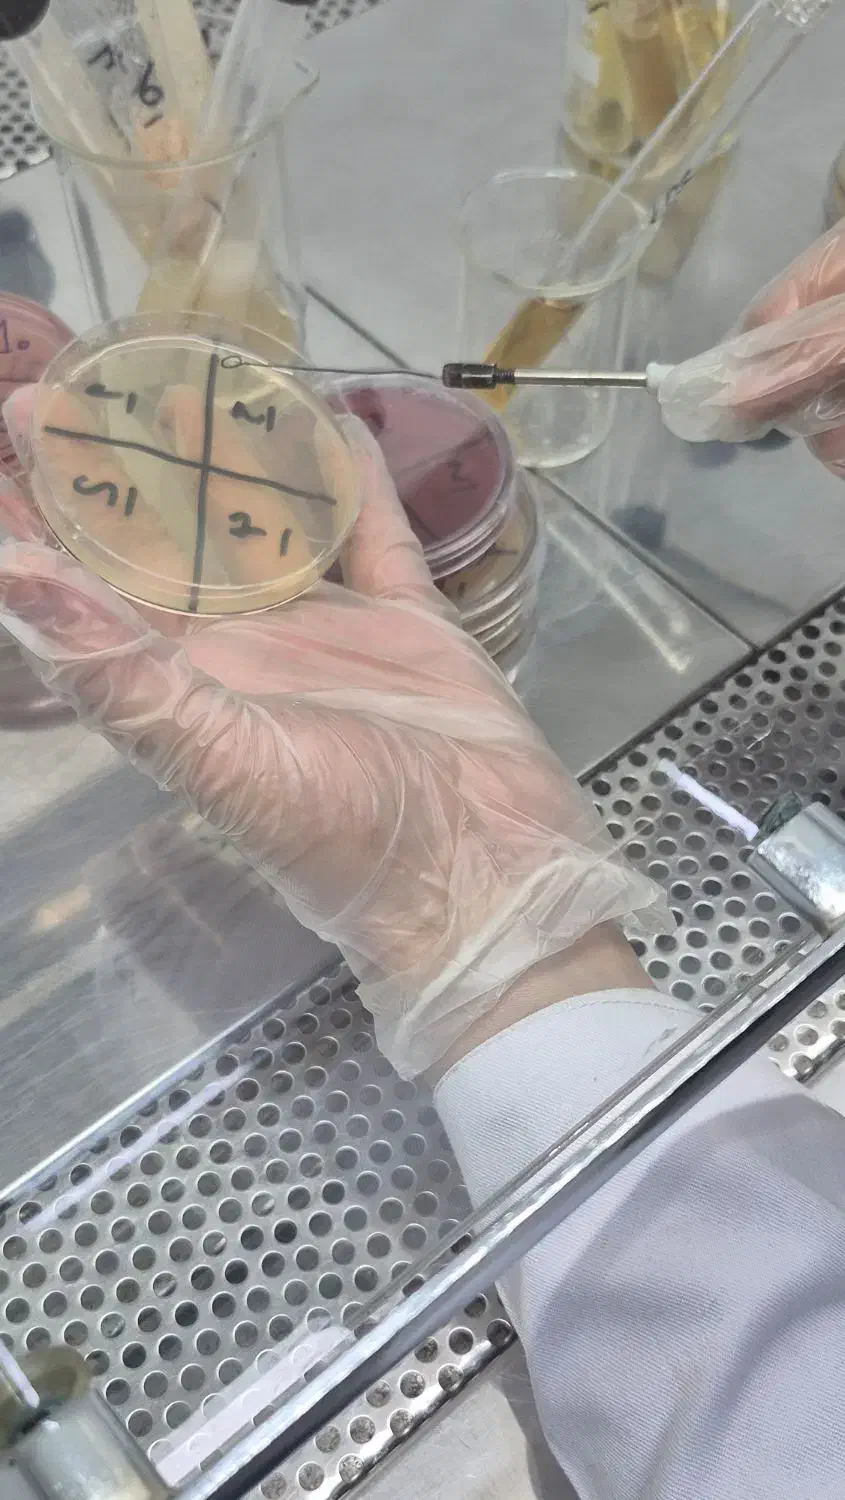
null

نشان کن
کد آگهی: KP2231407760
جذب نیروی آزمایشگاه و خط تولید
در اشتهارد - بلوار ابوریحان
اطلاعات شغل:
نوع همکاری: تماموقت
بیمه: دارد
نحوه پرداخت: ماهانه
ساعت کاری: از ۸ تا ۱۸ پنجشنبهها تا ظهر
متن کامل آگهی:
یک کارخانه معتبر آرایشی بهداشتی جهت تکمیل پرسنل خود نیازمند کارشناس میکروبیولوژی برای واحد آزمایشگاه (خانم)و تعدادی پرسنل تولید ساکن اشتهارد و بوئین زهرا(خانم) می باشد
حقوق اول هرماه
بیمه
سرویس و ناهار
شنبه تا چهارشنبه 8تا 18 پنجشنبه 8تا 17
استخدام صنعتی، فنی، مهندسی
این آگهی از وبسایت دیوار پیدا شده، با زدن دکمهی تماس با کارفرما، به وبسایت دیوار برین و از اونجا برای این شغل اقدام کنین.
هشدار
گزارش مشکل آگهی
تماس با کارفرما
این آگهی رو برای دیگران بفرست
نشان کن
گزارش مشکل آگهی
جستجوهای مرتبط
پنجشنبه 23 آبان 1404، ساعت 23:58